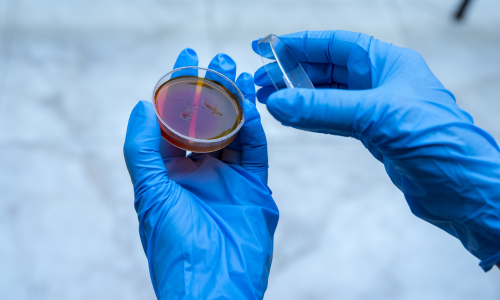

学術専門職員 <国立大学法人東京大学大学院理学系研究科附属臨海実験所>
- 三浦市
- 関東
- 神奈川
- 保育・教育系
- 学術専門職員
- パート・アルバイト
仕事内容
理学部・理学系研究科技術部に所属し、生命科学系・動物育成部門の業務に従事するが、日常業務は主として、附属臨海実験所において三浦半島沿岸域の海洋生物の採集と生物飼育補助、研究調査船(臨海丸)及び船外機付和船の運航補助を行う。
https://www.mmbs.s.u-tokyo.ac.jp/wp/
給与
【時給】1,300円〜1,400円
※資格、能力、経験等に応じて決定する。
*超過勤務手当
*通勤手当:月額上限55,000円
※資格、能力、経験等に応じて決定する。
*超過勤務手当
*通勤手当:月額上限55,000円
勤務地
〒238-0225
神奈川県三浦市三崎町小網代1024
神奈川県三浦市三崎町小網代1024
勤務時間・日数
9時00分〜17時00分
*休憩時間12:00~13:00
*時間外労働を命じることがある。
*週5日
*休憩時間12:00~13:00
*時間外労働を命じることがある。
*週5日
休日・休暇
*土曜日,日曜日,祝日
*年末年始(12月29日~1月3日)
*休暇:年次有給休暇、特別休暇等
*年末年始(12月29日~1月3日)
*休暇:年次有給休暇、特別休暇等
経験・資格
<経験>
不問
<資格・免許>
小型船舶操縦士:あれば尚可
潜水士:あれば尚可
普通自動車運転免許:必須(AT限定可)
不問
<資格・免許>
小型船舶操縦士:あれば尚可
潜水士:あれば尚可
普通自動車運転免許:必須(AT限定可)
待遇
【加入保険等】雇用保険,労災保険,健康保険,厚生年金
〇更新の有無
更新する場合があり得る。更新する場合は1年ごとに行うが、更新回数は9回、在職できる期間は、令和17年3月31日を 限度とし、以後更新しない。更新は予算の状況、従事している業務の進捗状況、契約期間満了時の業務量、勤務成績、勤務態度等を考慮のうえ判断する。
〇更新の有無
更新する場合があり得る。更新する場合は1年ごとに行うが、更新回数は9回、在職できる期間は、令和17年3月31日を 限度とし、以後更新しない。更新は予算の状況、従事している業務の進捗状況、契約期間満了時の業務量、勤務成績、勤務態度等を考慮のうえ判断する。
応募方法
〇提出書類:
(1)東京大学統一履歴書(以下のURLからダウンロードし作成すること)
https://www.u-tokyo.ac.jp/ja/about/jobs/r01.html
(2)職務経歴書(様式自由)
〇提出方法:
上記書類を電子メールで送信若しくは郵送してください。なお、連絡先として電子メールアドレスを記載してください。
【電子メール】メール件名を「学術専門職員応募書類」とすること
【郵送】封書に朱書で「学術専門職員応募書類」と明記のこと。
〇応募締切:令和7年10月24日(金)必着
書類選考のうえ、合格者に対して面接を実施。
(1)東京大学統一履歴書(以下のURLからダウンロードし作成すること)
https://www.u-tokyo.ac.jp/ja/about/jobs/r01.html
(2)職務経歴書(様式自由)
〇提出方法:
上記書類を電子メールで送信若しくは郵送してください。なお、連絡先として電子メールアドレスを記載してください。
【電子メール】メール件名を「学術専門職員応募書類」とすること
【郵送】封書に朱書で「学術専門職員応募書類」と明記のこと。
〇応募締切:令和7年10月24日(金)必着
書類選考のうえ、合格者に対して面接を実施。





